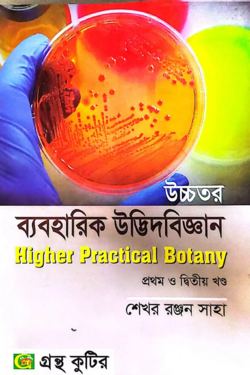
thumbnail

15

উচ্চতর ব্যবহারিক উদ্ভিদবিজ্ঞান (১ম ও ২য় ) - অনার্স ১ম বর্ষ - উদ্ভিদবিজ্ঞান বিভাগ - কোড--২১৩০০৬,২২৩০০৬
লেখক : অধ্যাপক শেখর রঞ্জন সাহা
প্রকাশনী : গ্রন্থ কুটির
বিষয় : উদ্ভিদবিজ্ঞান বিভাগ: অনার্স
পৃষ্ঠা : 460, সংস্করণ : 1st published, 2024
ভাষা : বাংলা
২৬৭৳৩১৫৳(১৫% ছাড়ে)
Wishlist
বন্ধুদের সাথে শেয়ার করুন
Share in social network
To reach the highest traffic view share this product
or copy link
আরো দেখুন…
সবগুলো দেখুন
উদ্ভিদ শারীরবিজ্ঞান - অনার্স ৩য় বর্ষ - উদ্ভিদবিজ্ঞান বিভাগ - কোড-২৩৩০০৩
সুনির্মল চন্দ্র বসু
৩১৮৳৩৭৫৳(১৫% ছাড়ে)

বাস্তুবিদ্যা ও পরিবেশবিজ্ঞান - অনার্স ৩য় বর্ষ - উদ্ভিদবিজ্ঞান বিভাগ - কোড-২৩৩০০৭
জীবন কৃষ্ণ সাহা
৩৪৮৳৪১০৳(১৫% ছাড়ে)

মেডিসিনাল প্লান্ট ও হারবাল মেডিসিন - মাস্টার্স ফাইনাল - কোড-৩১৩০২৭ - উদ্ভিদবিজ্ঞান বিভাগ
২৯৭৳৩৫০৳(১৫% ছাড়ে)
অফারে আরো যা পাচ্ছেন
৮৯৯+ টাকার অর্ডারে একটি মূল্যবান বই ফ্রি !
সর্বনিম্ন কেনাকাটা:৮৯৯ টাকা
মেয়াদ শেষ:১৭ এপ্রিল, ২০২৬
৪৯৯+ টাকার অর্ডারে ১টি বুকমার্ক ফ্রি !
সর্বনিম্ন কেনাকাটা:৪৯৯ টাকা
মেয়াদ শেষ:২৫ এপ্রিল, ২০২৬
রিভিউ এবং রেটিং
0.00
0 Ratings
0
0
0
0
0
Loading...








![উদ্ভিদবিজ্ঞান-১,(নন-মেজর-১) [ব্যবহারিকসহ] - অনার্স ১ম বর্ষ - উদ্ভিদবিজ্ঞান বিভাগ](https://wafilife-media.wafilife.com/uploads/2026/04/udvit-biggan-1-non-major-192x288.png)






